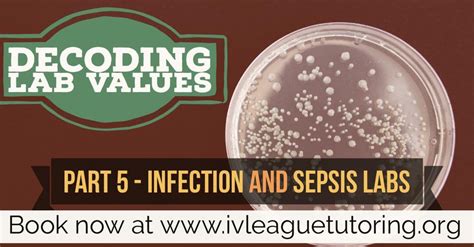

Sepsis ICD-10 Codes: Decoding The Deadly Infection
Sepsis ICD-10 Codes: Decoding the Deadly Infection
Hey guys, let’s dive into something super important today – sepsis and how it’s classified using ICD-10 codes . Sepsis, as you might know, is a really serious condition. It’s the body’s over-the-top, life-threatening response to an infection. When you have sepsis, your immune system goes into overdrive, and this can lead to widespread inflammation, tissue damage, and even organ failure. It’s crucial to understand what sepsis is, how it’s diagnosed, and how it’s tracked using the ICD-10 system. So, grab a seat, and let’s break it down together.
Table of Contents
Understanding Sepsis and Its Impact
First off, sepsis isn’t just a simple infection. It’s the body’s overwhelming reaction to an infection. Any type of infection – bacterial, viral, fungal, or parasitic – can trigger sepsis. The infection can start anywhere in the body: the lungs (pneumonia), the urinary tract (UTI), the skin, or even the abdomen. The tricky part is that sepsis can be tricky to spot early on. Symptoms can mimic other illnesses, making it essential for healthcare professionals to be vigilant. Symptoms can include things like a fever, chills, rapid heart rate, rapid breathing, and confusion. If the infection isn’t stopped quickly, it can cause severe tissue damage, organ failure, and in some cases, death. Because of its severity, it’s one of the leading causes of death in hospitals, affecting millions of people around the world.
Sepsis is not a single disease, but a syndrome caused by the body’s response to infection. This makes the condition tricky to treat, and treatment relies on quick diagnosis and aggressive treatment. The speed of diagnosis is important. The sooner it is diagnosed, the better the chances of survival and recovery. Sepsis can happen to anyone, but some people are at higher risk. These include older adults, people with weakened immune systems, those with chronic illnesses (like diabetes or kidney disease), and very young children. Prevention is key, which means practicing good hygiene, getting vaccinated, and seeking medical attention promptly if you suspect an infection. The impact on patients can be profound, resulting in long-term physical and cognitive problems for sepsis survivors. This is why understanding the condition is key to better care and outcomes.
The Role of ICD-10 in Diagnosing Sepsis
Now, let’s talk about ICD-10 . The International Classification of Diseases, 10th Revision (ICD-10), is a system developed by the World Health Organization (WHO) to classify diseases and health problems. It’s used by doctors, hospitals, and insurance companies worldwide to track and analyze health data. Think of ICD-10 codes as a universal language for medical diagnoses. Each code represents a specific condition, allowing healthcare providers to record and exchange information efficiently. ICD-10 codes are super important because they allow healthcare providers to track the incidence and prevalence of various diseases, including sepsis. They help to monitor public health trends and guide decisions about resource allocation and research.
When a patient is diagnosed with sepsis, doctors use specific ICD-10 codes to document the diagnosis. This helps healthcare professionals and researchers analyze data and to develop treatment strategies and improving patient care. The use of these codes can provide a common understanding of the severity of the disease and facilitates effective communication among healthcare professionals. The correct use of ICD-10 codes is crucial for accurate billing, reporting, and research. Without precise coding, it’s difficult to track the true impact of sepsis and to develop effective interventions. Different codes are used depending on the severity of the sepsis, the specific type of infection causing it, and the presence of any related complications, such as organ failure. This detailed coding allows for a more accurate assessment of the patient’s condition and guides appropriate treatment. For those who want to understand more about the details, you can find the coding manuals or ask your healthcare provider.
Decoding Specific ICD-10 Codes for Sepsis
Alright, let’s get into some of the specific ICD-10 codes used for sepsis. Keep in mind that these codes can get a little complex, but it’s important to have a general idea of how they work. The codes are structured to provide specific information about the condition, the causative organism, and any related complications. Here’s a basic breakdown. First, you have the main code for sepsis, which falls under the category of “septicemia”. Then, additional codes are used to specify the type of infection, the specific bacteria involved (if known), and any associated conditions. For example, you might see codes that indicate sepsis due to Staphylococcus aureus or sepsis related to a urinary tract infection.
For simple sepsis without major complications, you’ll see codes that generally fall under the A40-A41 range in the ICD-10 system. However, if the sepsis progresses to a more severe state, like severe sepsis or septic shock, the coding becomes more detailed. Severe sepsis is typically characterized by organ dysfunction. The codes used here would also capture the organ dysfunction. Septic shock is the most severe form of sepsis, leading to dangerously low blood pressure and organ failure. The ICD-10 codes used would reflect the severity of the condition and the specific organ systems affected. For instance, you might see codes for acute kidney failure, respiratory failure, or disseminated intravascular coagulation (DIC). Accurate coding for these severe conditions is essential for proper treatment and data analysis. If you’re a healthcare professional, the latest ICD-10 guidelines and coding manuals provide detailed guidance on the appropriate codes to use in various clinical scenarios. Proper use of these codes can provide a clear view of the disease and ensure that patients receive appropriate treatment and care.
Important Considerations and Next Steps
Okay, before we wrap things up, let’s look at some important considerations. Sepsis is not only a medical emergency, but it’s also a significant public health issue. Early recognition and prompt treatment are key to improving patient outcomes. The more people who are educated about the signs and symptoms of sepsis, the more lives that can be saved. If you suspect that you or someone you know has sepsis, seek medical attention immediately. Don’t wait! Prompt intervention, including antibiotics, fluids, and supportive care, can make all the difference.
ICD-10 codes are a crucial tool in the fight against sepsis. They help healthcare providers track the disease, monitor trends, and develop effective interventions. However, the correct use of these codes requires training and adherence to the latest guidelines. When it comes to sepsis, keep these things in mind:
- Early Detection : Be aware of the signs and symptoms of sepsis.
- Prompt Action : Seek medical care immediately if you suspect sepsis.
- Accurate Coding : Healthcare professionals should use the correct ICD-10 codes to document diagnoses.
- Continued Learning : Stay informed about the latest advances in sepsis treatment and coding.
By understanding sepsis and how it’s classified, we can work together to improve patient outcomes and reduce the impact of this deadly condition. Guys, let’s be vigilant and stay informed. That’s all for today. Stay healthy!